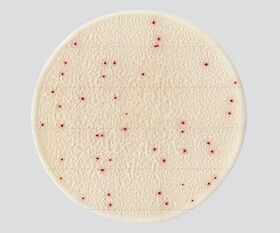

説明
【特徴】
●粉末培地の調製や事前のオートクレーブ滅菌が不要で、不意の検査にもすぐに対応できます。
●混釈・重層の必要がなく、作業時間も短縮可能です。
●発色剤を使用していますので、コロニーと残渣との判別が容易です。
●AOAC PTM認証・MicroVal認証・NordVal認証を取得しています。
●無料のソフトウェアと指定スキャナー(ADS-4300N、品番:65-9217-51)で、コロニーの自動カウントが可能です。
●自動カウントにより、業務の効率化に加えて、作業者によるバラつきや熟練度の影響も解消されます。
●★食品衛生検査指針 微生物編2018に収載されています。
●★一般生菌のコロニーは酸化還元指示薬により、明瞭な赤色を呈します。
●★標準寒天培地で広がりやすいBacillus属のコロニーが広がりづらく、視認性に優れています。
【仕様】
●型番:AC
●一般生菌数測定用
●入数:1箱(25枚/袋×4袋入)
●使用期限:製造から18ヶ月
●培養温度:35±1℃
●培養時間:48時間±2時間
●AOAC PTM認証・MicroVal認証・NordVal認証取得
●※保存方法:2~8℃
●※開封後は袋の端を2回以上折り返してテープで止め、冷蔵保存の上、3ヶ月以内に使用してください。
●※本品は日本国内向けのみの販売となります。
●★フィルム培地
追加情報
メーカー名:
キッコーマンバイオケミファ
メーカー品番:
61973
予定納期:
注文から1~3日で発送